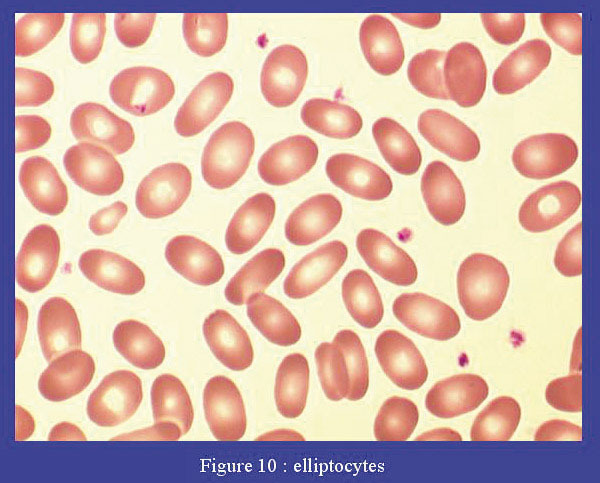

Les elliptocytes sont des globules rouges de forme ellipsoïdale ou ovale. Ils peuvent se rencontrer dans toutes les anémies. Une grande proportion d’elliptocytes doit faire suspecter une elliptocytose constitutionnelle, maladie héréditaire de la membrane des globules rouges. Elle se traduit par une anémie hémolytique de sévérité variable avec une splénomégalie. La pyropoïkilocytose héréditaire est une forme très sévère d’elliptocytose. Sur les frottis sanguins, elle est caractérisée par une poïkilocytose extrême avec peu d’elliptocytes.